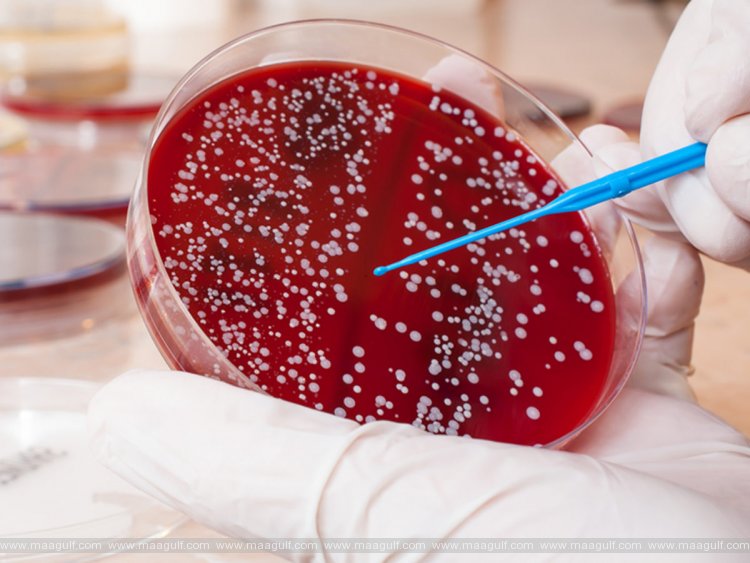
బ్లడ్ క్యాన్సర్ చికిత్సలో కార్ టి టెల్ థెరపీ సామర్థ్యాన్ని పరీక్షించనున్న యూఏఈ

బ్లడ్ క్యాన్సర్ చికిత్సలో కార్ టి టెల్ థెరపీ సామర్థ్యాన్ని పరీక్షించనున్న యూఏఈ
- September 25, 2021
అబుధాబి: అబుధాబిలోని ఓ రీసెర్చి ఇనిస్టిట్యూట్, బ్లడ్ క్యాన్సర్ చికిత్సలో ఇమ్యూనోథెరపీ వల్ల కలిగే ప్రయోజనాల గురించి ప్రయోగ పరీక్షలు నిర్వహిస్తోంది. ఈ ప్రాంతంలో ఇదే తొలి ప్రయోగం. అబుధాబి స్టెమ్ సెల్స్ సెంటర్ ఈ విషయాన్ని వెల్లడించింది. చిమెటిక్ యాంటిజెన్ రిసెప్టర్ టి సెల్ థెరపీ అనేది ప్రపంచ వ్యాప్తంగా గుర్తించబడిన ఇమ్యునోథెరపీ. కార్ టి సెల్ థెరపీ, శరీర డిఫెన్స్ సిస్టమ్ని ప్రేరేపిస్తుంది. టి సెల్స్ని రీ ప్రోగ్రామింగ్ చేస్తుంది. యాంటీ ట్యూమర్ రెస్పాన్స్ విషయంలో శరీరానికి సహకరించే అతి కీలక అంశమిది. క్యాన్సర్ కణాల్ని చంపడానికి ఉపకరిస్తుంది ఈ విధానం. రీ ప్రోగ్రామ్ చేయబడిన సెల్స్ సజీవంగా వున్న మందులా మారి, క్యాన్సర్ మీద పోరాడుతుంది.
తాజా వార్తలు
- కువైట్లో నెల రోజులపాటు క్లీనింగ్ క్యాంపెయిన్..!!
- సౌదీ డిజిటల్ ఆర్థిక వ్యవస్థపై సమగ్ర సర్వే ప్రారంభించిన GASTAT..!!
- ప్రాంతీయ భద్రత అంశంలో భారత్కు బహ్రెయిన్ కృతజ్ఞతలు..!!
- మసీర్హా పోర్టులో అగ్నిప్రమాదం.. వేగంగా స్పందించిన ఫైర్ ఫైటర్స్..!!
- నకిలీ వస్తువుల కొనుగోలుపై యూఏఈ హెచ్చరిక..రూ.2.3 కోట్ల వరకు జరిమానా, జైలు శిక్ష..!!
- ఖతార్లో చక్కెర కలిపిన పానీయాలపై ఎక్సైజ్ పన్ను అమలు..!!
- జకార్తాలో ప్రధాని మోదీకి ఘన స్వాగతం..
- జూలై 2027 వరకు యూఏఈ, జీసీసీ దేశాల ప్రయాణికులకు అర్మేనియా వీసా ఫ్రీ
- వర్సాన్లో పారిశుద్ధ్య కార్మికులకు దుబాయ్ పోలీసుల ‘షేడ్ అండ్ రివార్డ్’ కార్యక్రమం..
- దుబాయ్లో బస్సు సేవలకు AI ఆధారిత స్మార్ట్ సిస్టమ్..







